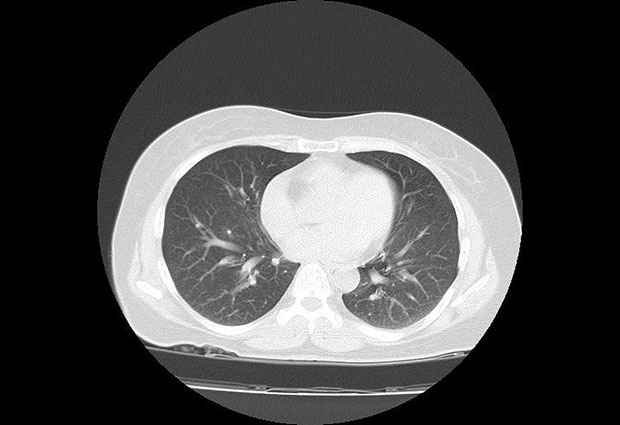
Лекари широм света БРУЈЕ о случају младе жене: Није имала ниједан симптом короне,а онда је снимак плућа ПОКАЗАО ОВО и хоспитализована је

Lekari širom sveta BRUJE o slučaju mlade žene: Nije imala nijedan simptom korone,a onda je snimak pluća POKAZAO OVO i hospitalizovana je
19. 04. 2020. u 20:43
Lekarska zajednica bruji o slučaju 30-godišnjakinje iz Australije koja je, nakon što joj se rođak zarazio i preminuo usled infekcije korona virusom, insistirala da joj se uradi snimak pluća
Lekae je nakon njenog upornog insistiranja pristao da joj uradi snimak iako, naglašava, osoba bez simptoma inače ne bi bila tako detaljno pregledala. A onda, nakon što je snimak urađen, usledilo je iznenađenje - delovi pluća nalikovali su zamagljenom staklu. To je bila tečnost i ukazivalo je na to da je mlada žena zaista zaražena korona virusom. U naredna dva dana, test je to i potvrdio, a ona je hospitalizovana.
Sliku njenih pluća objavila je Radiopedija, a snimak je objavio iranski radiolog dr Barham Rasuli.
- Insistirala je da joj se snime pluća jer je bila veoma zabrinuta nakon što joj je rođak umro. Lekar je, videvši koliko je napeta, pristao samo da bi je umirio i nekako utešio - komentariše dr Rasuli za portal ABC.
Snimak se sada deli među lekarskom zajednicom širom sveta.
- Veoma je važno da ovo vide radiolozi, ali i svi medicinski radnici širom sveta. Mnogo je asimptomatskih slučajeva zaraženosti, a kod nekih od njih odvijaju se ovako ozbiljni i teški upalni procesi - upozorava Endrju Dikson, radiolog iz bolnice Alfred u Melburnu.
(Blic žena)
Somborac
19.04.2020. 23:28
Hoće li već neko izaći sa istinim, kakav je ovo virus, ili šta god da je? Ovi nema veze sa gripom.






















Komentari (1)